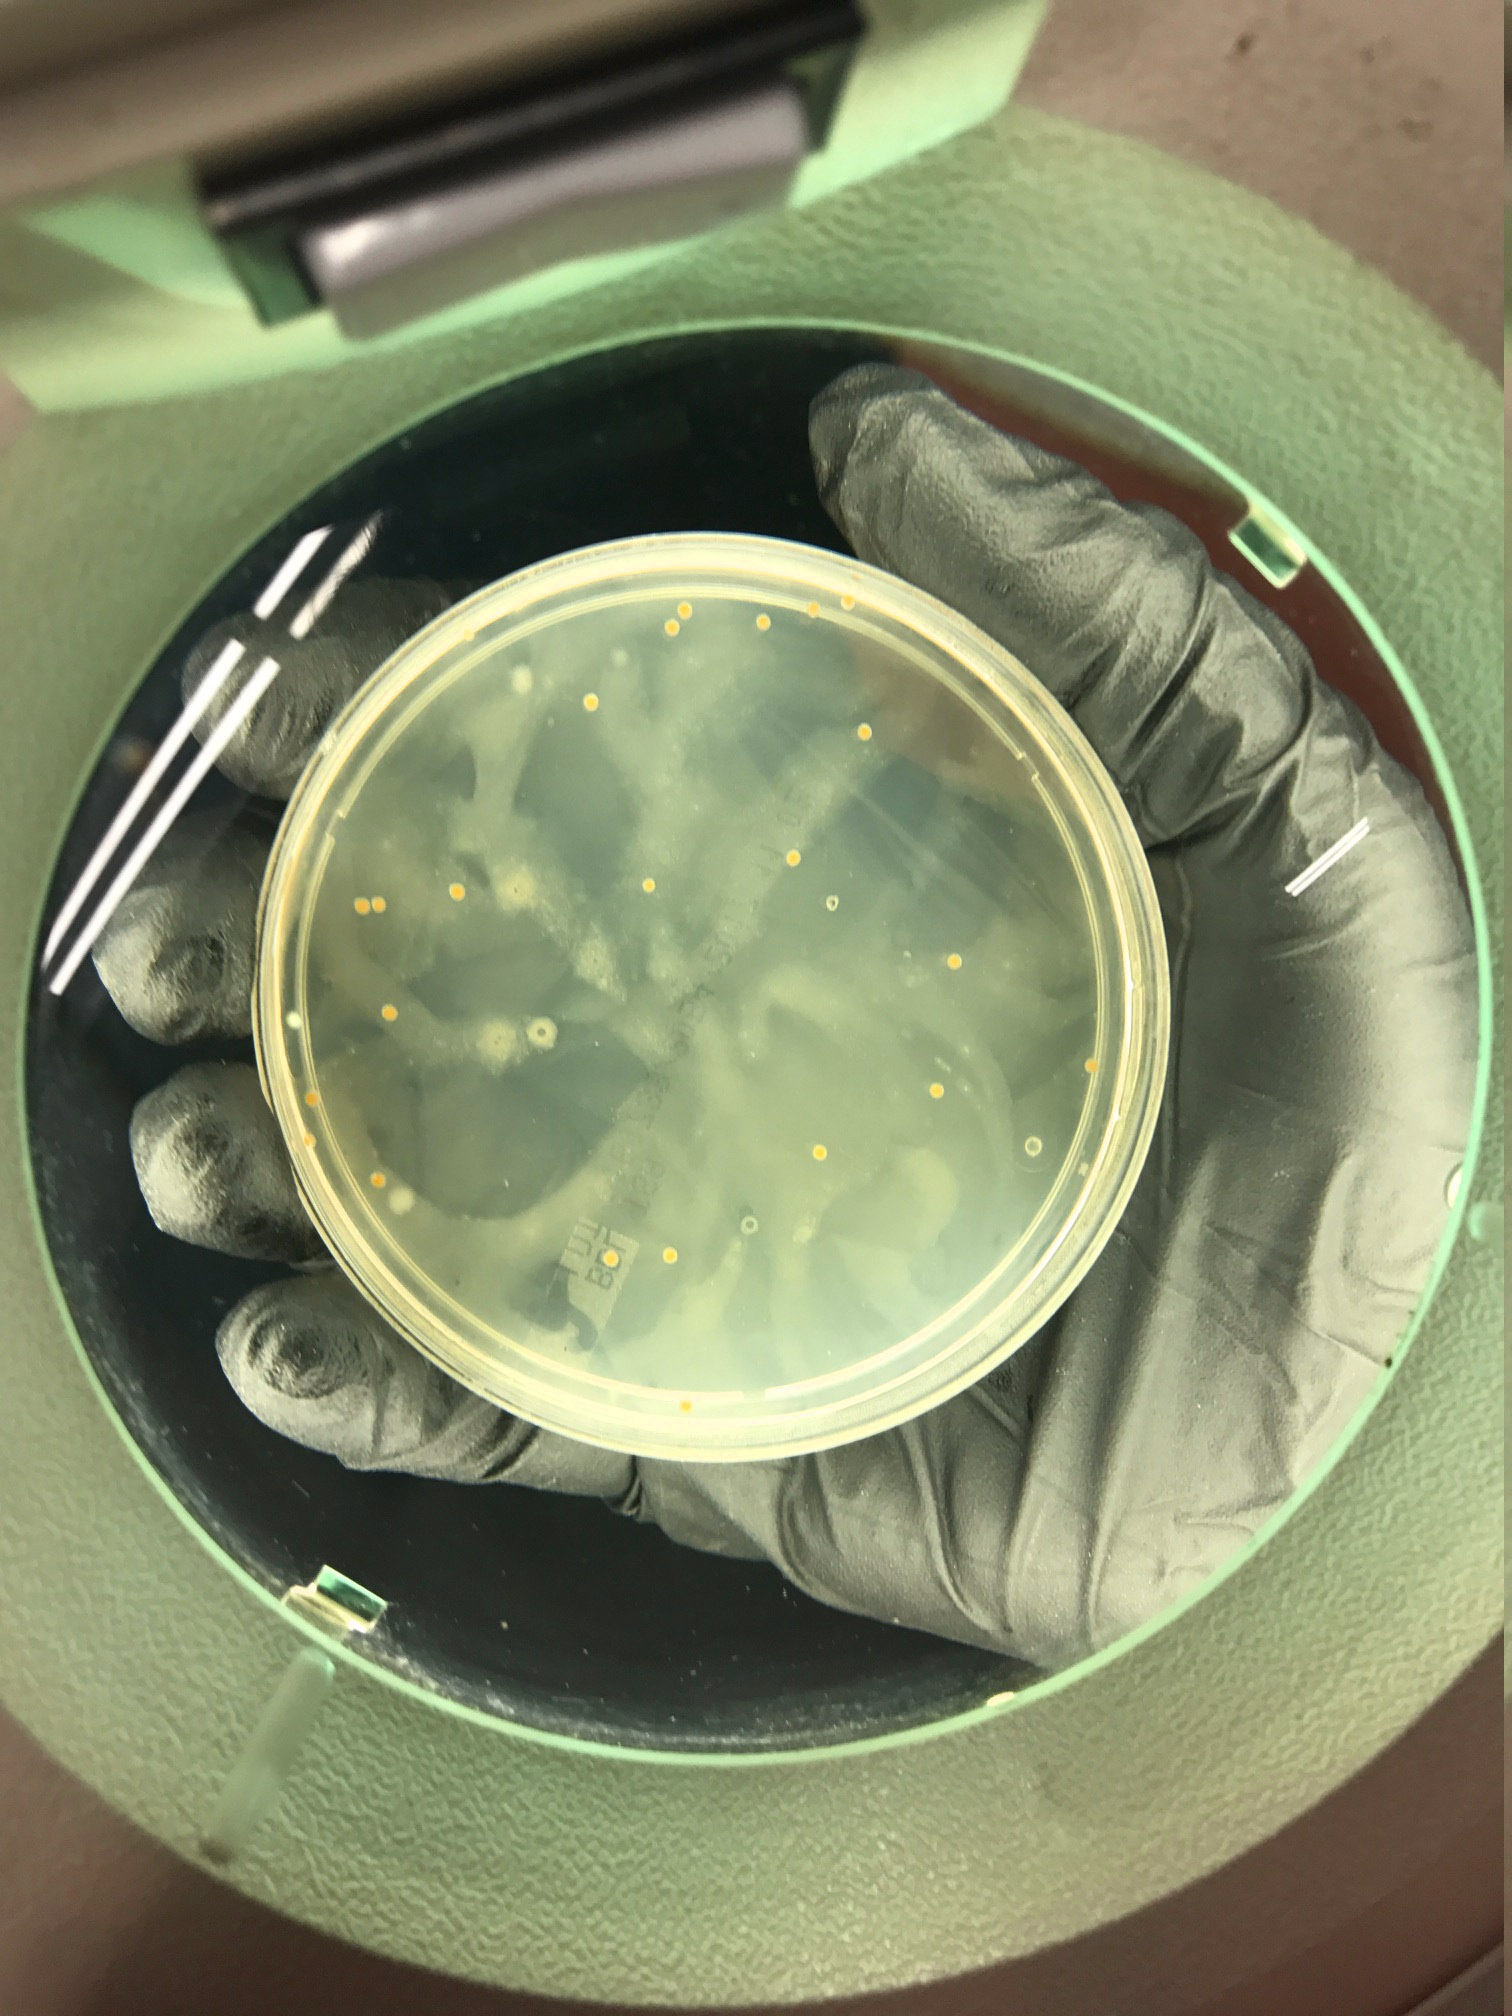

The International Journal of Environmental Microbiology does not typically accept submissions involving Brazilian jiu-jitsu apparel. But a sample taken from a blue Tatami gi belonging to Kyle Deering, 29, of Jacksonville, Florida, has prompted the journal’s editorial board to create a new submission category.
Deering, a four-stripe white belt at Coastal Grappling Academy, refers to the gi exclusively as “the lucky gi.” Independent microbiological analysis commissioned by a coalition of concerned training partners has identified 14 distinct bacterial colonies thriving across the garment’s collar, lapel, and sleeve cuffs. Three of those colonies have not been previously catalogued in any existing microbial database.
The gi has been washed 11 times since Deering purchased it in February 2025 — roughly once every five weeks, a frequency that microbiologist Dr. Elena Vasquez of the University of North Florida described as “anthropologically fascinating.”
“Most fabrics in sustained skin contact develop measurable bacterial loads within 48 hours of use,” Dr. Vasquez said in a phone interview. “This garment appears to have been sustaining continuous bacterial populations for intervals of 30 to 40 days between disruptions. Several colonies have developed structural stability we typically associate with biofilms found on medical implants.”
Dr. Vasquez’s team documented the 14 colonies in a preliminary report distributed to Coastal Grappling members via a shared Google Drive link that accumulated 340 views in the first four hours — approximately eight times the enrollment of the gym’s fundamentals program.
Three of the colonies have been provisionally designated Staphylococcus Petersenii, Corynebacterium Marshallense, and Brevibacterium Harkinsianum — named, per microbiological convention for novel organisms, after the individuals who first flagged the host specimen. In this case, those individuals are training partners Chris Petersen, Dana Marshall, and Kyle Harkins, who filed the three most detailed hygiene complaints with Coastal Grappling’s front desk between September and December 2025.
“I thought I had a rash,” said Petersen, a purple belt who regularly drills with Deering on Tuesday evenings. “Turns out I had a bacterial colony named after me. My dermatologist called it ‘a distinction’ and then referred me to infectious disease.”
Marshall, a blue belt, described the experience of being paired with Deering as “like rolling inside a sleeping bag someone left in a car for the summer.” She has since purchased a rashguard with antimicrobial threading that she wears exclusively on days Deering attends class. “It was $85,” she said. “I consider it PPE.”
The Smoothie Protocol
Deering’s training partners developed an informal compensation system in October 2025, shortly after the preliminary lab results were shared. The person assigned to drill with Deering during the technique portion of class receives a $5 smoothie from the remainder of the group after training. The payment is referred to internally as “hazard pay” and is tracked in a shared Notes app titled “The Rotation.”
“Nobody fights over drilling with Kyle anymore,” said Marcus Chen, a brown belt who manages the rotation schedule. “The system works. Everyone takes their turn. You do your twenty minutes, you get your smoothie, you shower immediately, and you don’t talk about it until it’s someone else’s turn.”
Chen confirmed that the smoothie fund has distributed $285 since its inception, averaging $5.70 per exposure. “We tried raising it to $7 during no-gi week,” he said. “Kyle sweats more without the gi. The market adjusted.”
The only member exempt from the rotation is 17-year-old blue belt Jaylen Torres, who secured permanent opt-out status after his mother emailed the gym’s front desk a three-paragraph message that Chen described as “legally adjacent.”
The Defense
When presented with the lab results during a conversation at the gym’s water fountain — positioned, Chen noted, at maximum possible distance from the mat — Deering disputed the findings’ relevance.
“Washing removes the grip texture,” Deering said, referring to what he described as a layer of accumulated friction on the gi’s collar and sleeves that improves his collar chokes. “You know how a new gi is slippery? Mine isn’t slippery. That’s not bacteria. That’s performance.”
Deering’s training partners confirmed that his submission rate has, in fact, increased since he adopted the reduced washing schedule. This is technically true. Over the past six months, most of his matches during live sparring have ended when his opponent voluntarily concedes position rather than engaging in sustained close-quarters contact.
“He’s not wrong about the submissions,” Petersen said. “I tapped from mount last week. He didn’t have anything locked in. I just couldn’t do it anymore.”
Deering’s Coastal Grappling competition record shows a 4-1 record since September 2025. Three of those wins came by submission, though a review of the available footage reveals that all three opponents exhibited visible discomfort and reduced engagement after initial grip exchanges in the collar-tie position. His lone loss came against an opponent who competed wearing a full-coverage rashguard under his gi and appeared unaffected.
“He beat three people who could smell him and lost to the one who couldn’t,” Chen said.
The Policy
Head instructor Tony Reeves posted a mandatory hygiene policy on January 3, 2026, after what he described as “an incident during a visitor’s first class that I’m not going to get into.” The policy, posted on the gym’s front door and emailed to all members, requires that all training apparel be washed after every use. It specifies one garment by color and brand: “the blue Tatami gi.”
“We didn’t want to name anyone specifically,” Reeves said. “But we needed to name the gi specifically. The gi is the problem. Kyle is a great training partner in every other respect. He shows up on time, he doesn’t spaz, he taps when he’s caught. He just thinks soap is optional.”
The policy also instituted a $25 mat fee for any member whose training apparel fails the “arm’s-length test,” defined in the document as “whether a reasonable person standing one arm’s length from the garment would describe the experience as unpleasant.” Deering has been assessed the fee three times. He disputes all three.

“Tony’s nose is sensitive,” Deering said. “I’ve asked multiple people and nobody’s said anything to my face.”
Chen declined to comment on this claim but noted that seven members have transferred to the Tuesday/Thursday schedule specifically because Deering trains Monday/Wednesday/Friday.
The Prognosis
Deering has read the hygiene policy. He does not believe it applies to him.
“Tony put that up because some people don’t wash their stuff,” Deering said. “I wash mine. Every five weeks, like clockwork. I have a system.”
When asked whether his system accounted for the three bacterial species named after his training partners, Deering paused for approximately four seconds.
“They should be honored,” he said. “Most people never get something named after them.”
The University of North Florida’s microbiology department has requested a follow-up sample to determine whether any of the three novel colonies have developed antibiotic resistance. Deering has agreed to provide one, on the condition that researchers do not apply any cleaning agents to the gi during the collection process.
“I don’t want them messing with the texture,” he said.
Staphylococcus Petersenii was formally submitted to the International Journal of Environmental Microbiology on March 14, 2026. Peer review is ongoing. Dr. Vasquez described the colony’s resilience as “remarkable” and noted that it has survived three local tournaments, two open mats, and a promotional seminar with a visiting black belt who has not returned to the gym.
Registration for the follow-up study closes April 30. Petersen, Marshall, and Harkins have all declined to participate. Deering signed up immediately.
“Free lab work,” he said. “Plus they said my name might be in the paper. Right next to the bacteria.”